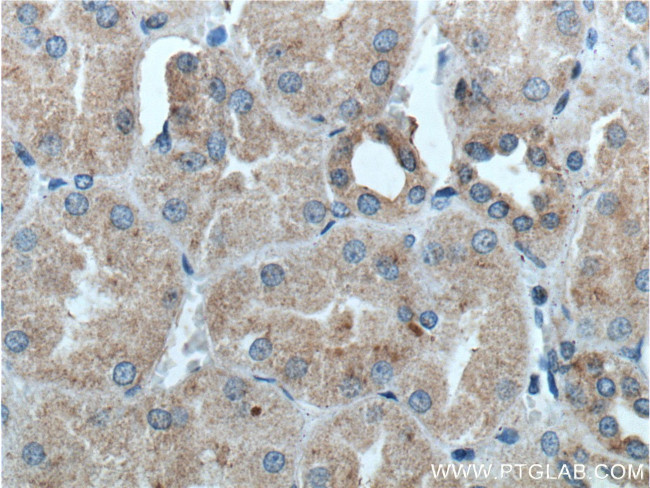
Kininogen 1 Antibody in Immunohistochemistry (Paraffin) (IHC (P))
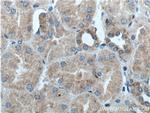
Kininogen 1 Antibody in Immunohistochemistry (Paraffin) (IHC (P))

Search
Proteintech
Kininogen 1 Polyclonal Antibody
{{$productOrderCtrl.translations['antibody.pdp.commerceCard.promotion.promotions']}}
{{$productOrderCtrl.translations['antibody.pdp.commerceCard.promotion.viewpromo']}}
{{$productOrderCtrl.translations['antibody.pdp.commerceCard.promotion.promocode']}}: {{promo.promoCode}} {{promo.promoTitle}} {{promo.promoDescription}}. {{$productOrderCtrl.translations['antibody.pdp.commerceCard.promotion.learnmore']}}
产品信息
27477-1-AP
种属反应
宿主/亚型
分类
类型
抗原
偶联物
形式
浓度
规格
纯化类型
保存液
内含物
保存条件
运输条件
产品详细信息
Immunogen sequence: ESQSEEIDC NDKDLFKAVD AALKKYNSQN QSNNQFVLYR ITEATKTVGS DTFYSFKYEI KEGDCPVQSG KTWQDCEYKD AAKAATGECT ATVGKRSSTK FSVATQTCQI TPAEGPVVTA QYDCLGCVHP ISTQSPDLEP ILRHGIQYFN NNTQHSSLFM LNEVKRAQRQ VVAGLNFRMT YS (20-200 aa encoded by BC060039)
靶标信息
This gene uses alternative splicing to generate two different proteins- high molecular weight kininogen (HMWK) and low molecular weight kininogen (LMWK). HMWK is essential for blood coagulation and assembly of the kallikrein-kinin system. Also, bradykinin, a peptide causing numerous physiological effects, is released from HMWK. In contrast to HMWK, LMWK is not involved in blood coagulation. Three transcript variants encoding different isoforms have been found for this gene.
仅用于科研。不用于诊断过程。未经明确授权不得转售。
篇参考文献 (0)
生物信息学
蛋白别名: Alpha-2-thiol proteinase inhibitor; bradykinin; Fitzgerald factor; High molecular weight kininogen; HMWK; Kininogen-1; prepro alpha-2-thiol proteinase inhibitor; unnamed protein product; Williams-Fitzgerald-Flaujeac factor
基因别名: BDK; BK; HAE6; HK; HMWK; KNG; KNG1
UniProt ID: (Human) P01042
Entrez Gene ID: (Human) 3827